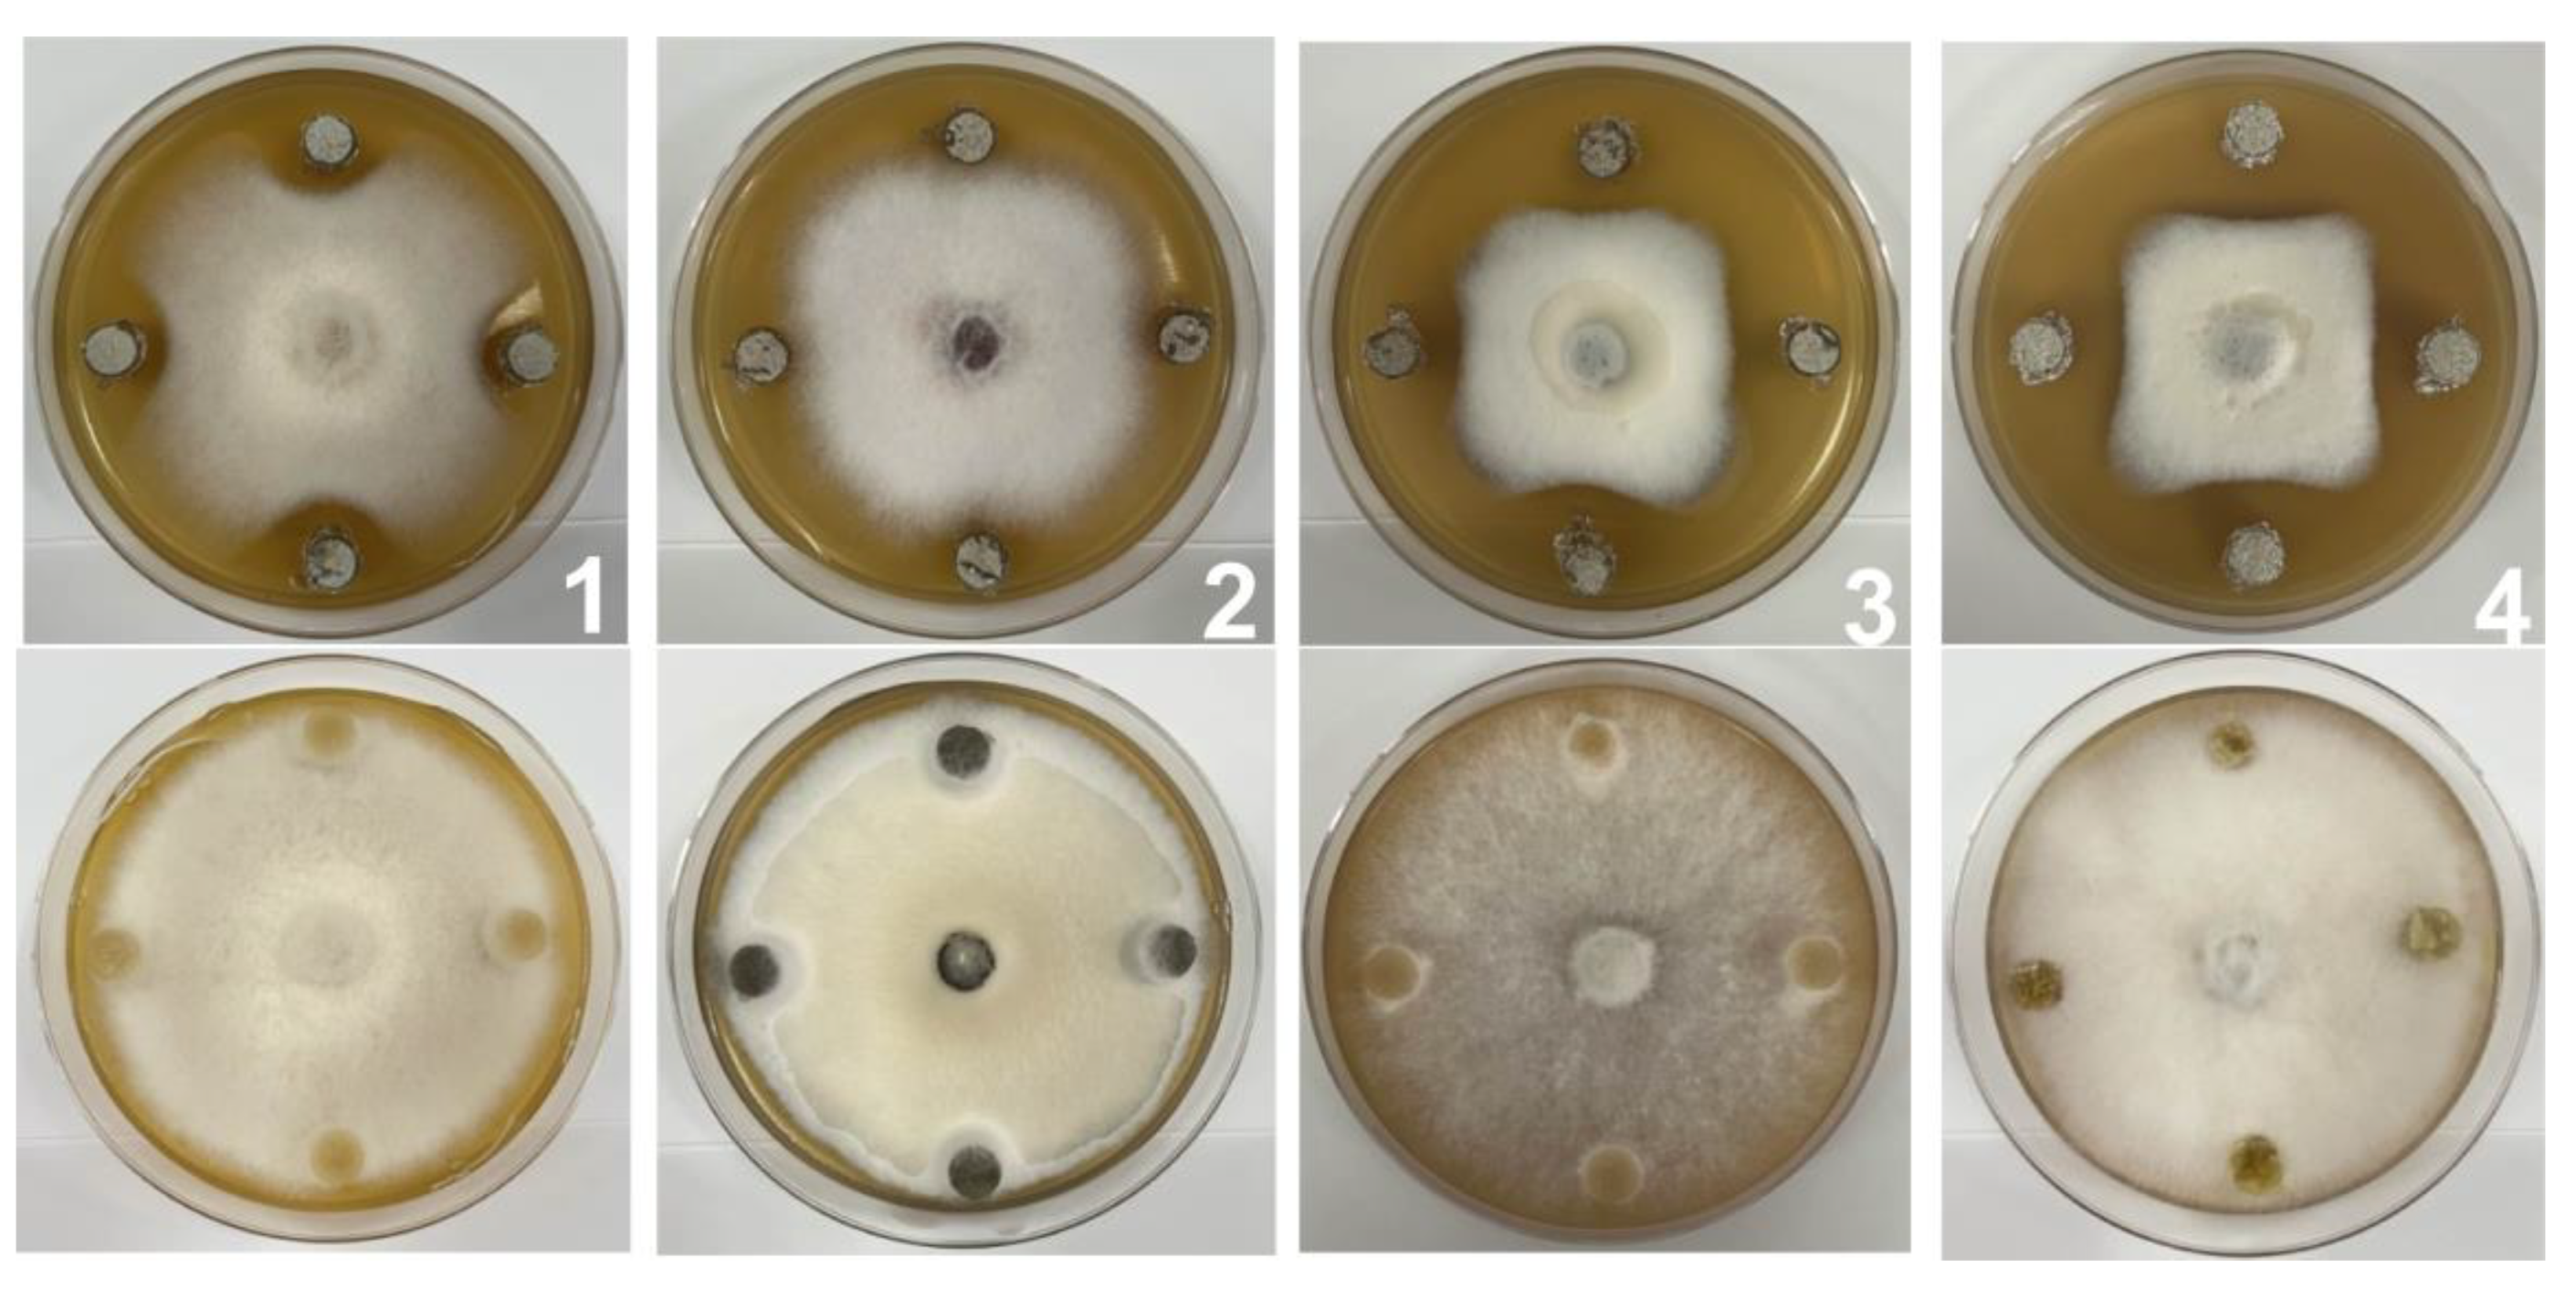
Ijms 24 17515 g003
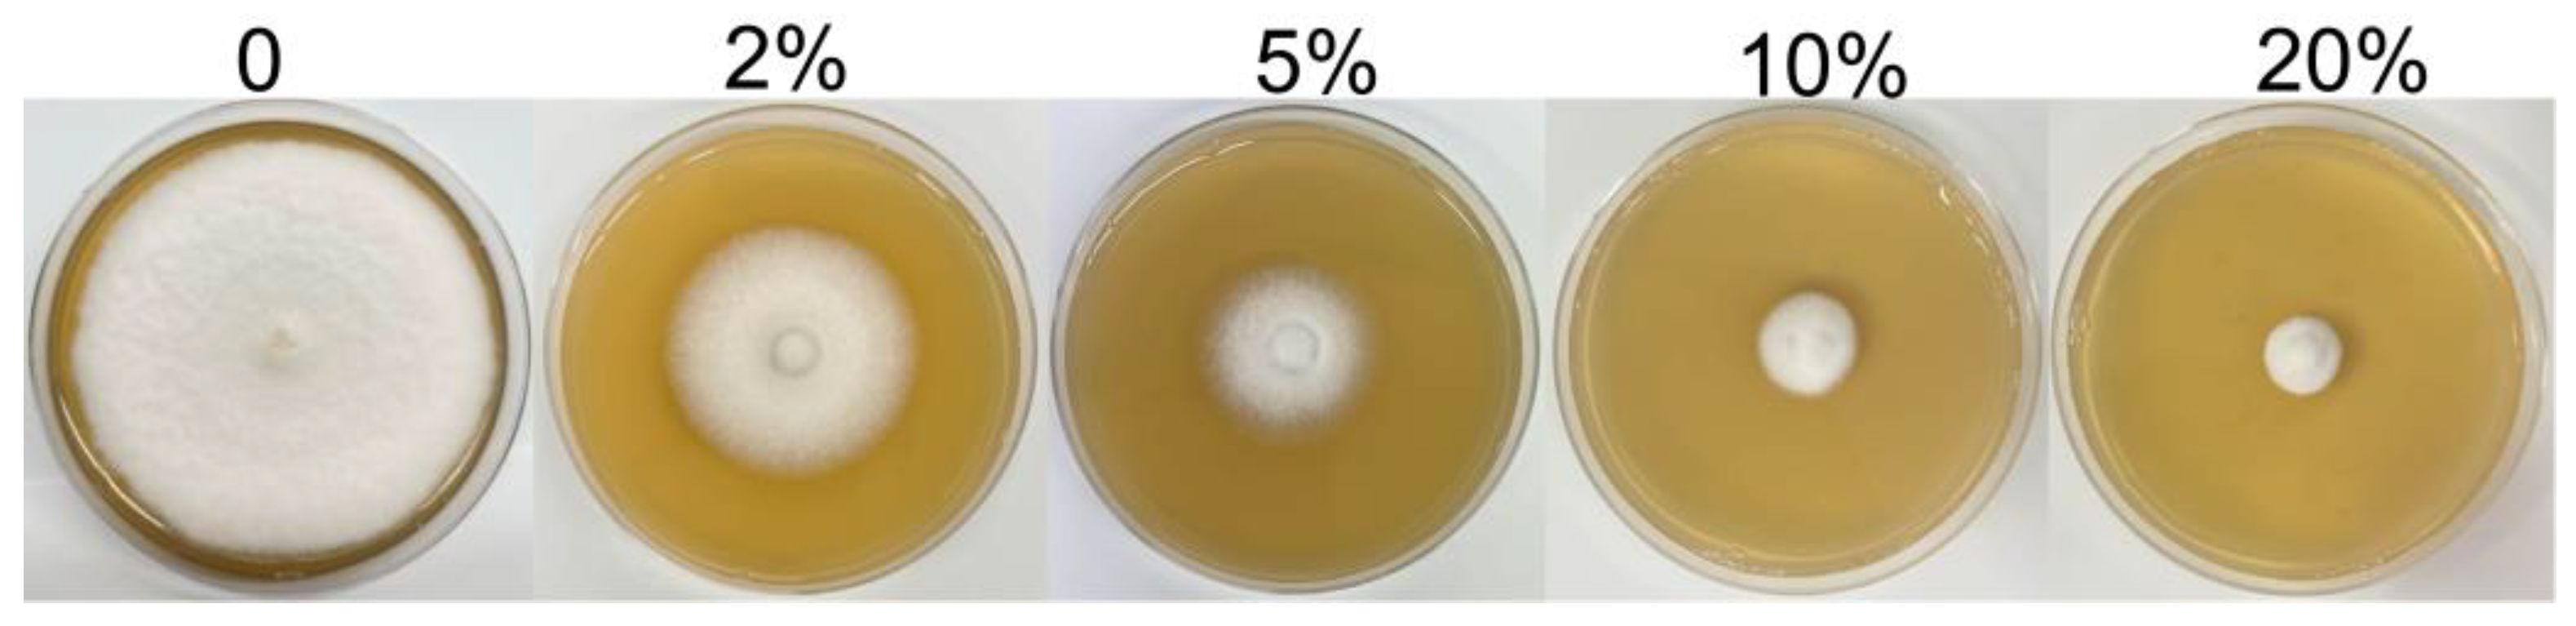
Ijms 24 17515 g004

Biocontrol Potential of Streptomyces odonnellii SZF-179 toward Alternaria alternata to Control Pear Black Spot Disease
Abstract
:1. Introduction
2. Results
2.1. Identification of the Fungal Pathogen
2.2. Screening and Identification of Rhizosphere Bacteria against A. alternata
2.3. Inhibitory Activity of SZF-179 against Plant Pathogens
2.4. Effect of SZF-179 Aseptic Filtrate (AF) on Mycelial Growth of A. alternata
2.5. Effect of SZF-179 on Mycelial Morphology by Ultra-Depth of Field Three-Dimensional Microscope
2.6. Identification of the Antifungal Polyene Compounds Containning Glycosyl Fragments
2.7. Thermal and pH Stability of SZF-179 Fermentation Broth
2.8. Biocontrol Effects of SZF-179 on Pear Leaves
2.9. Field Control Effects of SZF-179 on A. alternata
3. Discussion
4. Materials and Methods
4.1. Isolation and Identification of Fungal Pathogens
4.2. Isolation and Screening of Antagonistic Bacteria
4.3. Identification of Antagonistic SZF-179
4.4. Inhibition Spectrum of the Antagonistic SZF-179
4.5. Effect of SZF-179 on Mycelium Morphology of A. alternata
4.6. Evaluation of Antifungal Activity of SZF-179 AF against A. alternata
4.7. Analysis of the Secondary Metabolites from SZF-179 by UPLC-MS
4.8. PH and Thermal Stability of SZF-179 AF
4.9. Efficacy of SZF-179 for the Control of A. alternata on Pear Leaves
4.10. Field Assessment of the Biocontrol Efficacy of SZF-179 against Pear Black Spot Disease
4.11. Statistical Analysis
5. Conclusions
Author Contributions
Funding
Institutional Review Board Statement
Informed Consent Statement
Data Availability Statement
Acknowledgments
Conflicts of Interest
References
- Cho, Y. How the Necrotrophic Fungus Alternaria brassicicola Kills Plant Cells Remains an Enigma. Eukaryot Cell 2015, 14, 335–344. [Google Scholar] [CrossRef] [PubMed]
- Pinzari, F.; Cuadros, J.; Migliore, M.; Napoli, R.; Najorka, J. Manganese translocation and concentration on Quercus cerris decomposing leaf and wood litter by an ascomycetous fungus: An active process with ecosystem consequences? FEMS Microbiol. Ecol. 2018, 94, fiy111. [Google Scholar] [CrossRef]
- Llorente, I.; Moragrega, C.; Ruz, L.; Montesinos, E. An update on control of brown spot of pear. Trees 2012, 26, 239–245. [Google Scholar] [CrossRef] [PubMed]
- Ramirez-Villacis, D.X.; Barriga-Medina, N.; Llerena-Llerena, S.; Pazmino-Guevara, C.; Leon-Reyes, A. First Report of Alternaria alternata Causing Leaf Spot on Broccoli in Ecuador. Plant Dis. 2023, 107, 2866. [Google Scholar] [CrossRef] [PubMed]
- Zhong, F.T.; Liu, Y.L.; Zheng, D.; Lu, S. First report of Alternaria alternata causing brown leaf spot on wild rice (Oryza rufipogon) in China. Plant Dis. 2021, 106, 324. [Google Scholar] [CrossRef]
- Noelting, M.C.; Sisterna, M.N.; Sulyok, M.; Abbiati, N.N.; Molina, M.C. Damage caused by Alternaria alternata to the quality and germination of amaranth seeds. Eur. J. Plant Pathol. 2022, 163, 193–202. [Google Scholar] [CrossRef]
- Martinko, K.; Ivanković, S.; Lazarević, B.; Đermić, E. Control of Early Blight Fungus (Alternaria alternata) in Tomato by Boric and Phenylboronic Acid. Antibiotics 2022, 11, 320. [Google Scholar] [CrossRef]
- Li, W.; Huang, W.; Zhou, J.; Wang, J.; Liu, J.; Li, Y. Evaluation and control of Alternaria alternata causing leaf spot in soybean in Northeast China. J. Appl. Microbiol. 2023, 134, lxad004. [Google Scholar] [CrossRef]
- Fang, Q.; Wu, R.; Hu, G.; Lai, A.; Wu, K.; Zhang, L.; Feng, J.; Cao, H. Dissipation behavior, residue distribution and risk assessment of three fungicides in pears. J. Sci. Food Agric. 2020, 100, 1757–1763. [Google Scholar] [CrossRef]
- Li, Y.; Dong, F.; Liu, X.; Xu, J.; Li, J.; Kong, Z.; Chen, X.; Zheng, Y. Enantioselective determination of triazole fungicide tebuconazole in vegetables, fruits, soil and water by chiral liquid chromatography/tandem mass spectrometry. J. Sep. Sci. 2012, 35, 206–215. [Google Scholar] [CrossRef]
- He, M.H.; Wang, Y.P.; Wu, E.J.; Shen, L.L.; Yang, L.N.; Wang, T.; Shang, L.P.; Zhu, W.; Zhan, J. Constraining Evolution of Alternaria alternata Resistance to a Demethylation Inhibitor (DMI) Fungicide Difenoconazole. Front. Microbiol. 2019, 10, 1609. [Google Scholar] [CrossRef]
- Xu, C.; Zhang, J.; Zhou, J.; Zheng, Y.; Huang, W.; Qin, D.; Huo, J.; Li, Y. Identification, characterization and chemical management of Alternaria alternata causing blackcurrant leaf spot in China. J. Appl. Microbiol. 2023, 134, lxad025. [Google Scholar] [CrossRef]
- Ferreira-Pinto, M.M.; Moura-Guedes, M.C.; Barreiro, M.G.; Pais, I.; Santos, M.R.; Silva, M.J. Aureobasidium pullulansas a biocontrol agent of blue mold in “Rocha” pear. Commun. Agric. Appl. Biol. Sci. 2006, 71, 973–978. [Google Scholar]
- Gorordo, M.F.; Lucca, M.E. Biocontrol Efficacy of the Vishniacozyma Victoriae in Semi-Commercial Assays for the Control of Postharvest Fungal Diseases of Organic Pears. Curr. Microbiol. 2022, 79, 259. [Google Scholar] [CrossRef]
- Olanrewaju, O.S.; Babalola, O.O. Streptomyces: Implications and interactions in plant growth promotion. Appl. Microbiol. Biotechnol. 2019, 103, 1179–1188. [Google Scholar] [CrossRef]
- El-Saber Batiha, G.; Alqahtani, A.; Ilesanmi, O.B.; Saati, A.A.; El-Mleeh, A.; Hetta, H.F.; Magdy Beshbishy, A. Avermectin Derivatives, Pharmacokinetics, Therapeutic and Toxic Dosages, Mechanism of Action, and Their Biological Effects. Pharmaceuticals 2020, 13, 196. [Google Scholar] [CrossRef]
- Jian, X.; Pang, X.; Yu, Y.; Zhou, X.; Deng, Z. Identification of genes necessary for jinggangmycin biosynthesis from Streptomyces hygroscopicus 10–22. Antonie Leeuwenhoek 2006, 90, 29–39. [Google Scholar] [CrossRef]
- Yang, R.; Jiang, S.; Wen, X.; Song, X.; Wang, X.; Li, D.; Yin, Q.; Wu, X.; Wang, D.; Chen, Z. Antifungal Activity and Possible Mode of Action of Ningnanmycin Against Tea Gray Blight Disease Pathogen Pseudopestalotiopsis camelliae-sinensis. Phytopathology 2021, 111, 1735–1742. [Google Scholar] [CrossRef]
- Huang, M.; Wu, Z.; Li, J.; Ding, Y.; Chen, S.; Li, X. Plant Protection against Viruses: An Integrated Review of Plant Immunity Agents. Int. J. Mol. Sci. 2023, 24, 4453. [Google Scholar] [CrossRef]
- Yuan, W.M.; Crawford, D.L. Characterization of streptomyces lydicus WYEC108 as a potential biocontrol agent against fungal root and seed rots. Appl. Environ. Microbiol. 1995, 61, 3119–3128. [Google Scholar] [CrossRef]
- Law, J.W.; Ser, H.L.; Khan, T.M.; Chuah, L.H.; Pusparajah, P.; Chan, K.G.; Goh, B.H.; Lee, L.H. The Potential of Streptomyces as Biocontrol Agents against the Rice Blast Fungus, Magnaporthe oryzae (Pyricularia oryzae). Front. Microbiol. 2017, 8, 3. [Google Scholar] [CrossRef]
- de Azeredo, L.A.; Leite, S.G.; Freire, D.M.; Benchetrit, L.C.; Coelho, R.R. Proteases from actinomycetes interfere in solid media plate assays of hyaluronidase activity. J. Microbiol. Methods 2001, 45, 207–212. [Google Scholar] [CrossRef]
- Wright, P.A.; Wynford-Thomas, D. Koch’s postulates revisited. J. Pathol. 1991, 165, 355. [Google Scholar] [CrossRef]
- Bobek, J.; Filipová, E.; Bergman, N.; Čihák, M.; Petříček, M.; Lara, A.C. Polyenic Antibiotics and Other Antifungal Compounds Produced by Hemolytic Streptomyces Species. Int. J. Mol. Sci. 2022, 23, 15045. [Google Scholar] [CrossRef]
- Emma, T.; Perry, J.D.; Stanforth, S.P.; Dean, J.R. Identification of volatile organic compounds produced by bacteria using HS-SPME-GC-MS. J. Chromatogr. Sci. 2014, 52, 363–373. [Google Scholar]
- Skwarecki, A.S.; Skarbek, K.; Martynow, D.; Serocki, M.; Bylińska, I.; Milewska, M.J.; Milewski, S. Molecular Umbrellas Modulate the Selective Toxicity of Polyene Macrolide Antifungals. Bioconjug. Chem. 2018, 29, 1454–1465. [Google Scholar] [CrossRef] [PubMed]
- Wang, D.; Li, Y.; Yuan, Y.; Chu, D.; Cao, J.; Sun, G.; Ai, Y.; Cui, Z.; Zhang, Y.; Wang, F.; et al. Identification of non-volatile and volatile organic compounds produced by Bacillus siamensis LZ88 and their antifungal activity against Alternaria alternata. Biol. Control 2022, 169, 104901. [Google Scholar] [CrossRef]
- Al-Rahbi, B.A.A.; Al-Sadi, A.M.; Al-Mahmooli, I.H.; Al-Maawali, S.S.; Al-Mahruqi, N.M.T.; Velazhahan, R. Meyerozyma guilliermondii SQUCC-33Y suppresses postharvest fruit rot of strawberry caused by Alternaria alternata. Australas. Plant Pathol. 2021, 50, 349–352. [Google Scholar] [CrossRef]
- Verma, V.C.; Singh, S.K.; Prakash, S. Bio-control and plant growth promotion potential of siderophore producing endophytic Streptomyces from Azadirachta indica A. Juss. J. Basic. Microbiol. 2011, 51, 550–556. [Google Scholar] [CrossRef] [PubMed]
- Brautaset, T.; Sekurova, O.; Sletta, H.; Ellingsen, T.; Zotchev, S. Biosynthesis of the polyene antifungal antibiotic nystatin in Streptomyces noursei ATCC 11455: Analysis of the gene cluster and deduction of the biosynthetic pathway. Chem. Biol. 2000, 7, 395–403. [Google Scholar] [CrossRef]
- Deng, Z.; Hu, Z.; Tao, M.; Bao, K.; Zhou, X.; Zhou, Q.; Hopwood, D.A.; Kieser, T. A Giant Gene Cluster for an Antifungal Antibiotic and Its Potential Relevance to Rice Biotechnology. In Rice Genetics III: (In 2 Parts); World Scientific: Singapore, 1996. [Google Scholar] [CrossRef]
- Gunji, S.; Arima, K.; Beppu, T. Screening of antifungal antibiotics according to activities inducing morphological abnormalities. Agri. Biol. Chem. 1983, 47, 2061–2069. [Google Scholar]
- Wang, B.; Guo, Y.; Chen, X.; Ma, J.; Lei, X.; Wang, W.; Long, Y. Assessment of the Biocontrol Potential of Bacillus velezensis WL–23 against Kiwifruit Canker Caused by Pseudomonas syringae pv. actinidiae. Int. J. Mol. Sci. 2023, 24, 11541. [Google Scholar] [CrossRef]
- Bi, Q.; Liu, P.; Wu, J.; Lu, F.; Han, X.; Wang, W.; Zhao, J. Transcriptomic and Metabolomic Analysis of the Mechanism by which Bacillus tequilensis Inhibits Alternaria alternata to Control Pear Black Spot. Biol. Control 2023, 187, 105394. [Google Scholar] [CrossRef]
- Getha, K.; Vikineswary, S. Antagonistic effects of Streptomyces violaceusniger strain G10 on Fusarium oxysporum f.sp. cubense race 4: Indirect evidence for the role of antibiosis in the antagonistic process. J. Ind. Microbiol. Biotechnol. 2002, 28, 303–310. [Google Scholar] [CrossRef]
- Manhas, R.K.; Kaur, T. Biocontrol Potential of Streptomyces hydrogenans Strain DH16 toward Alternaria brassicicola to Control Damping Off and Black Leaf Spot of Raphanus sativus. Front Plant Sci. 2016, 7, 186. [Google Scholar] [CrossRef]
- Sharifi, F.; Bonjar, G.H.S.; Aghighi, S.; Farrokhi, P.R.; Taraz, H. Antagonistic Potential of Iranian Native Streptomyces Strains in Biocontrol of Pythium aphanidermatum. J. Biol. Res. 2007, 32, 1041–1043. [Google Scholar]
- Zacky, F.A.; Ting, A.S.Y. Investigating the bioactivity of cells and cell-free extracts of Streptomyces griseus towards Fusarium oxysporum f. sp. cubense race 4. Biol. Control 2013, 66, 204–208. [Google Scholar] [CrossRef]
- Fu, M.; Crous, P.W.; Bai, Q.; Zhang, P.F.; Xiang, J.; Guo, Y.S.; Zhao, F.F.; Yang, M.M.; Hong, N.; Xu, W.X.; et al. Colletotrichum species associated with anthracnose of Pyrus spp. in China. Persoonia 2019, 42, 1–35. [Google Scholar] [CrossRef]
- El Karkouri, A.; Assou, S.A.; El Hassouni, M. Isolation and screening of actinomycetes producing antimicrobial substances from an extreme Moroccan biotope. Pan Afr. Med. J. 2019, 33, 329. [Google Scholar] [CrossRef]
- Hammami, R.; Oueslati, M.; Smiri, M.; Nefzi, S.; Ruissi, M.; Comitini, F.; Romanazzi, G. Epiphytic Yeasts and Bacteria as Candidate Biocontrol Agents of Green and Blue Molds of Citrus Fruits. J. Fungi 2022, 8, 818. [Google Scholar] [CrossRef]
- Kumar, S.; Stecher, G.; Tamura, K. MEGA7: Molecular Evolutionary Genetics Analysis Version 7.0 for Bigger Datasets. Mol. Biol. Evol. 2016, 33, 1870–1874. [Google Scholar] [CrossRef] [PubMed]
- Dong, H.; Gao, R.; Dong, Y.; Yao, Q. Bacillus velezensis RC116 Inhibits the Pathogens of Bacterial Wilt and Fusarium Wilt in Tomato with Multiple Biocontrol Traits. Int. J. Mol. Sci. 2023, 24, 8527. [Google Scholar] [CrossRef] [PubMed]
- Jin, L.; Feng, S.; Tang, S.; Dong, P.; Li, Z. Biological control of potato late blight with a combination of Streptomyces strains and biochar. Biol. Control 2023, 183, 105248. [Google Scholar] [CrossRef]

| Pathogens | Relative Inhibition Rate (%) |
|---|---|
| Colletrichum gloeosporioides | 36.62 ± 0.80 c |
| Fusarium oxysporum f. sp. lycopersici | 42.62 ± 0.80 b |
| Pythium aphanidermatum | 50.97 ± 0.67 a |
| Alternaria alternata | 55.04 ± 0.31 a |
| Staphylococcus aureus | — |
| Micrococcus luteus | — |
| Escherichia coli DH10B | — |
| Treatment | Diameter in mm a | Relative Inhibition Rate (%) b |
|---|---|---|
| Control c | 77.62 ± 0.40 a | — |
| 2%AF | 50.75 ± 0.27 b | 34.62 ± 0.80 d |
| 5%AF | 29.52 ± 0.18 c | 61.97 ± 0.67 c |
| 10%AF | 20.15 ± 0.06 c | 74.04 ± 0.31 b |
| 20%AF | 9.25 ± 0.47 d | 88.08 ± 0.34 a |
| Treatment (cells/mL) | Lesion Diameter (cm) a | Inhibition Rate (%) b |
|---|---|---|
| Control c | 0.632 ± 0.198 a | —— |
| 1 × 106 | 0.492 ± 0.198 b | 22.15 ± 0.98 c |
| 1 × 107 | 0.411 ± 0.076 b | 34.97 ± 0.76 b |
| 1 × 108 | 0.365 ± 0.078 c | 42.25 ± 1.24 a |
| Cultivar | Treatment | Disease Index |
|---|---|---|
| Hosui | SZF-179 fermentation broth | 1.55 b |
| 10% difenoconazole 2000× diluent | 1.30 b | |
| water | 2.31 a | |
| Wonwhang | SZF-179 fermentation broth | 0.79 b |
| 10% difenoconazole 2000× diluent | 0.70 b | |
| water | 1.09 a |
Disclaimer/Publisher’s Note: The statements, opinions and data contained in all publications are solely those of the individual author(s) and contributor(s) and not of MDPI and/or the editor(s). MDPI and/or the editor(s) disclaim responsibility for any injury to people or property resulting from any ideas, methods, instructions or products referred to in the content. |
© 2023 by the authors. Licensee MDPI, Basel, Switzerland. This article is an open access article distributed under the terms and conditions of the Creative Commons Attribution (CC BY) license (https://creativecommons.org/licenses/by/4.0/).
Share and Cite
Zhang, F.; Wen, S.; Wang, B.; Zhang, Z.; Liu, F.; Ye, T.; Wang, K.; Hu, H.; Yang, X.; Fang, W. Biocontrol Potential of Streptomyces odonnellii SZF-179 toward Alternaria alternata to Control Pear Black Spot Disease. Int. J. Mol. Sci. 2023, 24, 17515. https://doi.org/10.3390/ijms242417515
Zhang F, Wen S, Wang B, Zhang Z, Liu F, Ye T, Wang K, Hu H, Yang X, Fang W. Biocontrol Potential of Streptomyces odonnellii SZF-179 toward Alternaria alternata to Control Pear Black Spot Disease. International Journal of Molecular Sciences. 2023; 24(24):17515. https://doi.org/10.3390/ijms242417515
Chicago/Turabian StyleZhang, Fei, Shaohua Wen, Beibei Wang, Zhe Zhang, Fang Liu, Ting Ye, Kaimei Wang, Hongju Hu, Xiaoping Yang, and Wei Fang. 2023. "Biocontrol Potential of Streptomyces odonnellii SZF-179 toward Alternaria alternata to Control Pear Black Spot Disease" International Journal of Molecular Sciences 24, no. 24: 17515. https://doi.org/10.3390/ijms242417515
APA StyleZhang, F., Wen, S., Wang, B., Zhang, Z., Liu, F., Ye, T., Wang, K., Hu, H., Yang, X., & Fang, W. (2023). Biocontrol Potential of Streptomyces odonnellii SZF-179 toward Alternaria alternata to Control Pear Black Spot Disease. International Journal of Molecular Sciences, 24(24), 17515. https://doi.org/10.3390/ijms242417515





